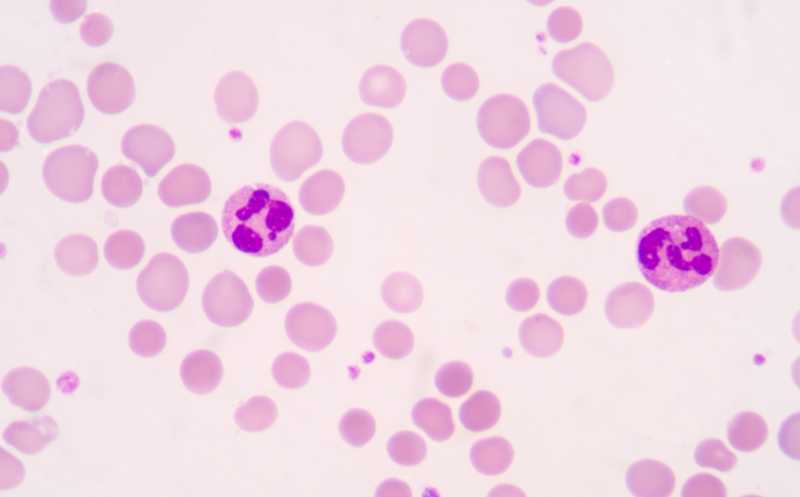

Клональный гемопоэз ассоциирован с развитием атеросклероза
Мутации в гемопоэтической стволовой клетке могут дать преимущество ее потомкам, из-за которого их число в крови человека непропорционально нарастает. Это явление называется клональным гемопоэзом. Ученые из Испании установили, что мутации, связанные с клональным гемопоэзом, увеличивают риск развития атеросклероза. Высокопроизводительное секвенирование выявило такие мутации примерно у 25% людей в возрасте 40–55 лет.
Соматические мутации, накапливающиеся в течение жизни человека, могут способствовать развитию различных заболеваний. Наиболее ярким примером является клональный гемопоэз (КГ) — состояние, при котором новые соматические мутации в гемопоэтических стволовых клетках (ГСК) дают им селективное преимущество, что приводит к клональному разрастанию мутантной клетки. Мутации, связанные с КГ, затрагивают ограниченное число генов — чаще всего эпигенетические регуляторные гены DNMT3A и TET2, которые также часто мутируют при гематологических новообразованиях. Кроме того, КГ рассматривается как общий фактор риска для растущего списка негематологических расстройств. Исследования показывают связь атеросклеротических сердечно-сосудистых заболеваний (ССЗ) с клональным гемопоэзом. Однако до сих пор не было известно, является ли ускоренный атеросклероз причиной или следствием КГ.
Ученые из Испании исследовали связь между клональным гемопоэзом и атеросклерозом при помощи секвенирования ДНК клеток крови и неинвазивной сосудистой визуализации. Они обнаружили, что наличие мутаций, связанных с клональным гемопоэзом, увеличивает риск возникновения атеросклероза в течение шести лет, тогда как атеросклероз никак не влияет на появление новых мутаций.
Предыдущие исследования с использованием полногеномного и полноэкзомного секвенирования показали, что КГ редко встречается у людей среднего возраста (2–3%, тогда как у людей старше 65 лет — 10%). Но можно предположить, что низкая чувствительность секвенирования не позволяла выявить малочисленные клоны.
Авторы новой работы провели высокочувствительное таргетное секвенирование 54 генов, связанных с КГ, у 3692 человек в возрасте 40–55 лет, с медианной глубиной покрытия 3712×. Им удалось идентифицировать более тысячи мутаций, ассоциированных с клональным гемопоэзом; хотя бы одну мутацию имел примерно каждый четвертый участник. Наиболее частыми были мутации в гене DNMT3A (657 мутаций, 14,7% участников), за ними следовали мутации в гене TET2 (153 мутации, 3,9%). Распространенность мутаций КГ в этой популяции увеличивалась с возрастом. Мутации в DNMT3A у женщин встречались на 64% чаще, чем у мужчин. Ожидаемо, численность клонов была гораздо меньше, чем в предыдущих исследованиях; доля подавляющего большинства клонов не превышала 2%.
Затем исследователи изучили патофизиологические эффекты мутаций у участников исследования. Наличие мутаций, связанных с КГ, было связано с более высокими абсолютными количествами клеток крови во всех линиях гемопоэза, что показал многофакторный регрессионный анализ с учетом возраста и пола. Носители мутаций КГ были склонны к более высокому артериальному давлению и повышенному уровню гликированного гемоглобина HbA1C, что соответствует данным некоторых предыдущих исследований. Однако эти ассоциации не оказались статистически значимыми после корректировки по возрасту и полу. Также не было обнаружено статистически значимой ассоциации между КГ и субклинической атеросклеротической нагрузкой (бессимптомный атеросклероз, определяется гистологически как патологическое утолщение интимы с накоплением липидов).
Далее ученые оценили, повышен ли риск атеросклероза у людей, у которых выявлены мутации, связанные с КГ. Действительно, наличие мутаций было связано с 1,5-кратным увеличением риска развития атеросклероза в бедренной артерии через три года у участников, у которых на момент начала наблюдения этого диагноза не было. Величина эффекта зависела от размера мутантного клона: более крупные клоны увеличивали риск в 2,1 раза, что сопоставимо с влиянием таких хорошо известных факторов риска, как дислипидемия или курение. При этом ассоциация не зависела от общего количества клеток крови. Эффект КГ в основном был обусловлен мутациями в генах, связанных с миелоидным клональным гемопоэзом, которые увеличивали риск развития атеросклероза в 1,6 раза. Мутации в генах DNMT3A и TET2 также были связаны с повышенным риском.
Наконец, команда исследовала динамику КГ у здоровых людей среднего возраста, чтобы проверить, влияет ли на нее наличие и (или) выраженность атеросклероза. Однако динамика КГ не зависела ни от наличия или степени атеросклероза, ни от традиционных факторов риска, таких как дислипидемия, диабет, курение или ожирение.
Таким образом, клональный гемопоэз увеличивает риск развития атеросклероза у людей среднего возраста, но обратной зависимости не показано — атеросклероз не влияет на гемопоэз. Авторы надеются, что эти данные будут полезны при подборе терапии для пациентов как с КГ, так и с атеросклерозом.
Клональный гемопоэз ассоциирован с первичным, но не повторным инфарктом миокарда
Источник
Díez-Díez M., et al. Unidirectional association of clonal hematopoiesis with atherosclerosis development // Nature Medicine (2024). DOI: 10.1038/s41591-024-03213-1


 Меню
Меню





 Все темы
Все темы




 0
0












